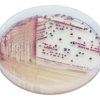
CHROMagar Vibrio

Description
Colonies Appearance

V. parahaemolyticus
Mauve

V. vulnificus / V. cholerae
Green-blue to turquoise blue

V. alginolyticus
Creamy
Performance
Naturally present on marine plants and animals, Vibrio genus counts over 20 species among which four represent a serious public health hazard.
V. cholerae often cause cholera through water and food contamination. Emerging cyclically, cholera is considered to be endemic in many countries as a virulent disease causing severe diarrhea and dehydration. The number of cholera cases reported to the W.H.O. in 2006 rose dramatically, reaching the level of the 1990s. Around 240,000 cases were reported from 52 countries, including about 6300 deaths.
V. parahaemolyticus and V. vulnificus are largely involved in foodborne diseases from seafood, causing septicaemia, wound infections, and gastroenteritis. CDC reports an estimated 47 % increase of Vibrio infections in the US (1996-1998 to 2008), about 8000 illnesses yearly. Vibrio infections are also commonly reported in areas of Asia and Oceania, linked to the high consumption of seafood. Despite the fact that V. parahaemolyticus is the most commonly reported species causing infection, V. vunificus has become increasingly prevalent and is now associated with 94 % of reported deaths.
V. alginolyticus is less common but is a pathogen concern for oyster producers since it can lead to major production losses. If detected, it can prevent contamination of other oyster production sites.
1. Different clear and intense colonie colours : thanks to its powerful chromogenic technology. Easy reading especially when compared to the conventional TCBS medium based on sucrose fermentation revealed with a pH indicator.
2. Pratical : V. alginolyticus remains colourless in CHROMagar™ Vibrio, avoiding any interference with the detection of other species.
3. Clear differentiation : between V. parahaemolyticus and V. vulnificus, both sucrose (-) on TCBS.
4. Powerful : Unrivalled medium in the chromogenic media field.
5. Excellent recovery : greater than with TCBS agar, even if using an enrichment broth. Fewer false negatives than with TCBS agar.
Composition